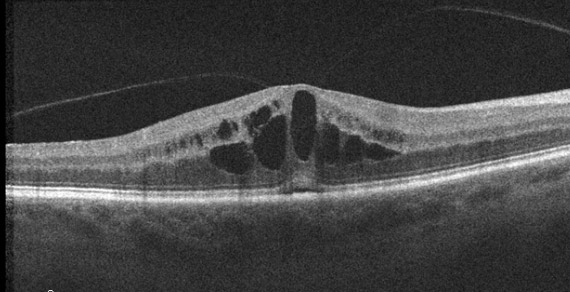

OCT Academy
OCT Mastery – Tip of the Week
New OCT Mastery and other clinical tips are added each week. As a new user, you will get them in your inbox.
146. Poor vision after Motor Vehicle Accident (MVA)

Sanjay Sharma MD, MSc (Epid), MBA
Professor of Ophthalmology, Queen’s University
This patient lost their vision after an MVA. Why?
ANALYSIS
In this image there is evidence of vitreomacular adhesion. In the center of the image, there is intraretinal fluid in the inner nuclear layer and at the junction between the outer plexiform/nuclear layer. There is also some subretinal fluid. The patient’s angiogram demonstrates a petaloid pattern (video). The ellipsoid is a little thickened centrally.
This patient was diagnosed with whiplash maculopathy.
OCT Tip
In a large vessel that courses through the macula, consider a CRM.